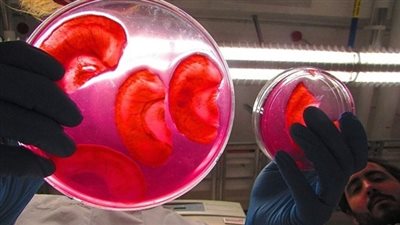
قريبا.. بيع

عاجل
الحفل قرب.. القنوات الناقلة لافتتاح المتحف المصري الكبير مهد الحضارات وخزائن التاريخ
بث مباشر.. مباراة الاتحاد ضد الخليج في الدوري السعودي وموعد اللقاء
القنوات المصرية تنقل حفل افتتاح المتحف المصري الكبير للعالم لحظة بلحظة
القنوات الناقلة لافتتاح المتحف المصري الكبير 2025 بث مباشر بجودة HD
أحمد موسى: المتحف المصري الكبير عمل دعاية بمليارات الدولارات لمصر